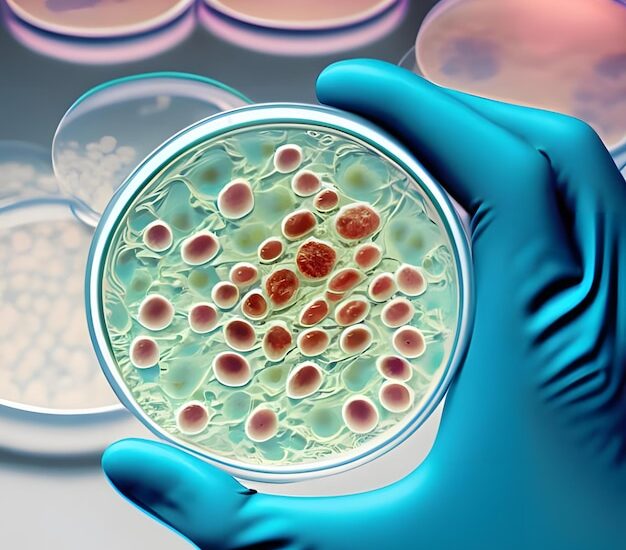
Cell Regeneration Medicine Market

According to Future Market Insights’ newly released Cell Regeneration Medicine Market analysis report, the global market valuation stands at US$ 30.3 Billion in 2021 and is expected to be valued at US$ 34.3 Billion by the end of 2022. The market is expected to rise significantly at a CAGR of 14.4% and the global valuation is expected to be US$ 130.8 Billion by the end of 2032. During the forecasted period (2022-2032), the global market is anticipated to offer an absolute dollar opportunity of US$ 96.5 Billion.
The Therapeutics segment is predicted to be the top product segment in the Cell Regeneration Medicine Market with an expected CAGR of 16.5% for the period between 2022 and 2032. This is significantly higher from the historical CAGR of 14.1% owing to higher adoption of primary cell-based therapies in clinical application and their increased usage in different therapeutic indications.
To Get Sample Copy of Report with Complete TOC, Figures & Graphs Connect with us @ https://www.futuremarketinsights.com/reports/sample/rep-gb-15084
Furthermore, Cell Regeneration Medicine garners highest revenue through the Oncology segment, which accounts for over a quarter share. The market revenue through Oncology segment is expected to experience the CAGR of 13.1% in the therapeutic category as compared to its historical average of 11.4%. The category is expected to rise due to high cancer prevalence, increasing investments in cancer research, development of advanced cell therapies and initiatives to reduce cancer burden.
Revenue of Cell Regeneration Medicine Market from 2017 to 2021 Compared to Demand Outlook for 2022 to 2032
As per the publications released by Future Market Insights – market research and competitive intelligence provider, on Cell Regeneration Medicine Market, the market is currently valued at US$ 30.3 Billion in 2021 and is expected to rise at a CAGR of 14.4% during the period between 2022 and 2032. This growth has been significantly higher than the historical growth of 12.4%. The market is expected to offer an absolute dollar opportunity of US$ 96.5 Billion between 2022 and 2032. By the end of 2032, the global market for Cell Regeneration Medicine is likely to hit the valuation of US$ 130.8 Billion.
The market valuation is projected to grow at a significant CAGR of 14.4% as compared to historical CAGR of 12.4% owing to factors such as introduction of gene therapy, advancements in stem cell and tissue engineering, ongoing funding in R&D by government and commercial entities and continuous regulatory approvals for advanced therapeutic medical products.
- The Cell Regeneration Medicine Market was valued at US$ 30.3 Billion in 2021 and is expected to reach the valuation of US$ 34.3 Billion by the end of 2022.
- During 2017-2021, the demand Cell Regeneration Medicine demand grew at a CAGR of 12.4%.
- By the end of 2032, the global market will reach a valuation of US$ 130.8 Billion by growing at a CAGR of 14.4% between 2022 and 2032.
- Cell Regeneration Medicine market is projected to grow by 3.8X during the period between 2022 and 2032.
- The Therapeutics segment dominates the global market for Cell Regeneration Medicines and is expected to remain a dominant segment with a CAGR of 16.5% during the period between 2022 and 2032.
- The Oncology segment is expected to be the largest revenue grosser throughout the analysis period which is expected to grow at a CAGR of 13.1% during the forecast period.
- The U.S. market dominates the global market for the Cell Regeneration Medicines with nearly 40% share and is expected to increase at a CAGR of 14.2% during the forecast period.
What Factors are driving the Growth of Cell Regeneration Medicine Market?
Global Cell Regeneration Medicine Market is likely to be driven by the introduction of gene therapy, advancements in stems cells and growth in tissue engineering. Furthermore, various projects like T-Cell therapy, which comes under the manufacturing industry of cell therapy regenerative medicine are being undertaken by any businesses in cooperation with other businesses or research institutions. Furthermore, the government regulatory approvals has led to increase in the market growth.
Gain Valuable Insights Through Our Cutting-Edge Methodology Today! https://www.futuremarketinsights.com/request-report-methodology/rep-gb-15084
The global pandemic has provided the global players with various chances to bring medicinal solution to fight against SARS-COV-2. Along with various initiatives, the ongoing investments by government and private sector agencies in R&D has accelerated the industry’s advancement. Companies are collaborating to expand their R&D skills to develop and sell innovative therapies to secure a position in a competitive global market.
Researchers’ perspectives on Cell Regeneration Medicine have been transformed by technological developments like Nanotechnology, 3D bioprinting techniques and AI in stem cell-based therapeutics. These developments are making dermatological grafting operations like persistent burns, bone aBillionormalities and skin wounds more efficient. The market is being driven by the rising frequency of chronic medical conditions and genetic aBillionormalities such as congestive heart failure, myocardial infarction, Parkinson’s disease and various kinds of bone losses. In addition, the growing elderly population suffering from musculoskeletal, oncological and cardiological problems is driving market expansion.
Competitive Analysis
A number of companies invested in the development of cell regenerative medicine to meet demand for clinical needs without resorting to more-invasive procedures. The market is extremely competitive, and players are making joint efforts for product development.
Some of the prominent Cell Regeneration Medicine manufacturers are AstraZeneca plc, Astellas Pharma, Inc., F. Hoffmann-La Roche Ltd., Integra Lifesciences Corp., Cook Biotech, Inc., Bayer AG, Pfizer, Inc., Merck KGaA, Abbott, Vericel Corp., Novartis AG, GlaxoSmithKline (GSK), Baxter International, Inc., Takara Bio, Inc.
The recent developments in the Global Cell Regeneration Medicine Market are:
- In January 2022, AstraZeneca collaborated with Neurimmune AG and signed the licence agreement for the development of NI006, an antibody to treat patients with advanced ATTR-CM.
- In October 2021, FDA approved the REGEN-COV on a priority basis for the treatment of Covid 19.
Market Segments Covered in Cell Regeneration Medicine Market Analysis
By Product Type:
- Therapeutics
- Primary Cell-based Therapeutics
- Stem Cell & Progenitor Cell-based Therapeutics
- Cell-based Immunotherapies
- Gene Therapies
- Tools
- Banks
- Services
By Therapeutic Category:
- Dermatology
- Musculoskeletal
- Immunology & Inflammation
- Oncology
- Cardiovascular
- Ophthalmology
- Other Therapeutic Categories
By Region:
- North America
- Latin America
- Europe
- APAC
- MEA
About Future Market Insights (FMI)
Future Market Insights, Inc. (ESOMAR certified, Stevie Award – recipient market research organization and a member of Greater New York Chamber of Commerce) provides in-depth insights into governing factors elevating the demand in the market. It discloses opportunities that will favor the market growth in various segments on the basis of Source, Application, Sales Channel and End Use over the next 10-years.
Contact Us:
Future Market Insights Inc.
Christiana Corporate, 200 Continental Drive,
Suite 401, Newark, Delaware – 19713, USA
T: +1-845-579-5705
For Sales Enquiries: sales@futuremarketinsights.com
Website: https://www.futuremarketinsights.com
LinkedIn| Twitter| Blogs | YouTube